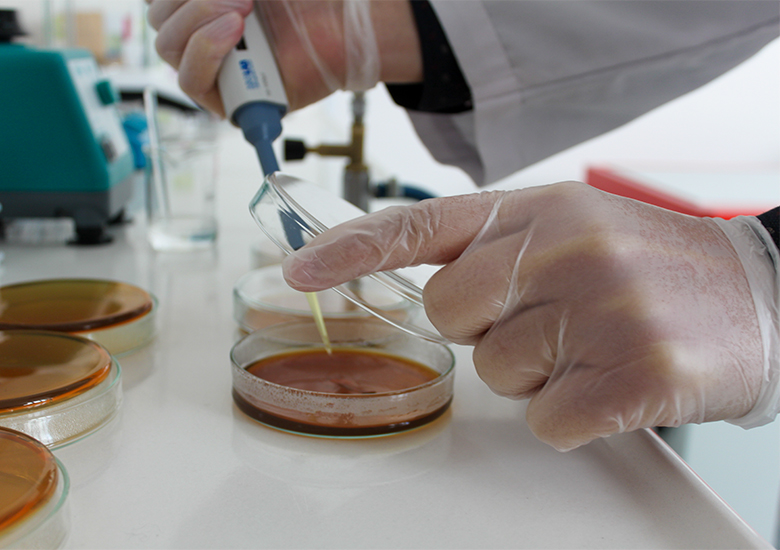

LifeBact
Yaşam Veren Bakteriler

Probiyotik Bakteriler
Vita-

Dare

Bacteria
Biyotek Arge Biyoteknoloji
Şirketimiz, gıda, sağlık, hayvancılık ve tarım alanlarında inovatif araştırma ve geliştirme çalışmaları gerçekleştirmektedir. Özellikle probiyotikler alanında yaptığımız ar-ge çalışmaları sonucunda ortaya çıkardığımız yenilikçi ürünlerle ülkemizin ve insanımızın sağlığına katkıda bulunuyoruz.
Yenilikçi, kaliteli ürünlerimizi, uzman ekibimizle birleştirerek müşterilerimize sunduğumuz hizmet kalitemizi her geçen gün arttırıyoruz.
Ürünlerimiz
Elde ettiğimiz özgün probiyotik bakteri suşlarımızın kaynağı, ülkemizin zengin doğal gıda kaynaklarıdır. Bu eşsiz suşları endüstriyel ölçekte toz formda üretme kabiliyetimiz sayesinde, yerli üretimle ülkemize değer katıyoruz.
Sağlıklı ve doğal bir beslenmenin önemini benimseyen her bireyin kullanımına sunabileceğimiz ürünlerimizle, hayat kalitesini artırmaya devam ediyoruz.
Çalışmalarımız
Şirketimiz, insan ve hayvan sağlığını olumlu yönde etkileyen probiyotiklerin yanı sıra, silaj/yem kalitesinin artırılmasına yönelik çalışmalar, ekşi hamur mayası, mikrobiyal gübre ve benzeri konularda da araştırma ve geliştirme faaliyetleri yürütmektedir.
Yenilikçi çözümlerimiz sayesinde, gıda, tarım ve hayvancılık sektöründe kaliteli ve verimli ürünler elde etmek, çevre dostu uygulamalarla doğal kaynakları korumak ve sürdürülebilir bir gelecek için çalışmak amacındayız.
Ülkemize özgü probiyotik bakteri suşlarının izolasyonu ve endüstriyel ölçekte ilk kez yerli üretiminin gerçekleştirilmesi konusunda yaptığımız projeler başarılı şekilde tamamlanmıştır.
Ekibimiz
Çalışmalarımız, alanında uzman kişiler tarafından planlanarak projelendirilmektedir. Proje bazlı yaklaşımımızla, her projenin ihtiyaçlarına göre özenle seçtiğimiz tecrübeli ekip üyelerimiz ile çalışmalarımız yürütülmektedir.
CEO
Eren BAYGIN
Arge Çalışanı
Şeyma Öztürk
Danışma Kurulu
Dr. Aytaç KOCABAŞ
Dr. Murat DOĞAN